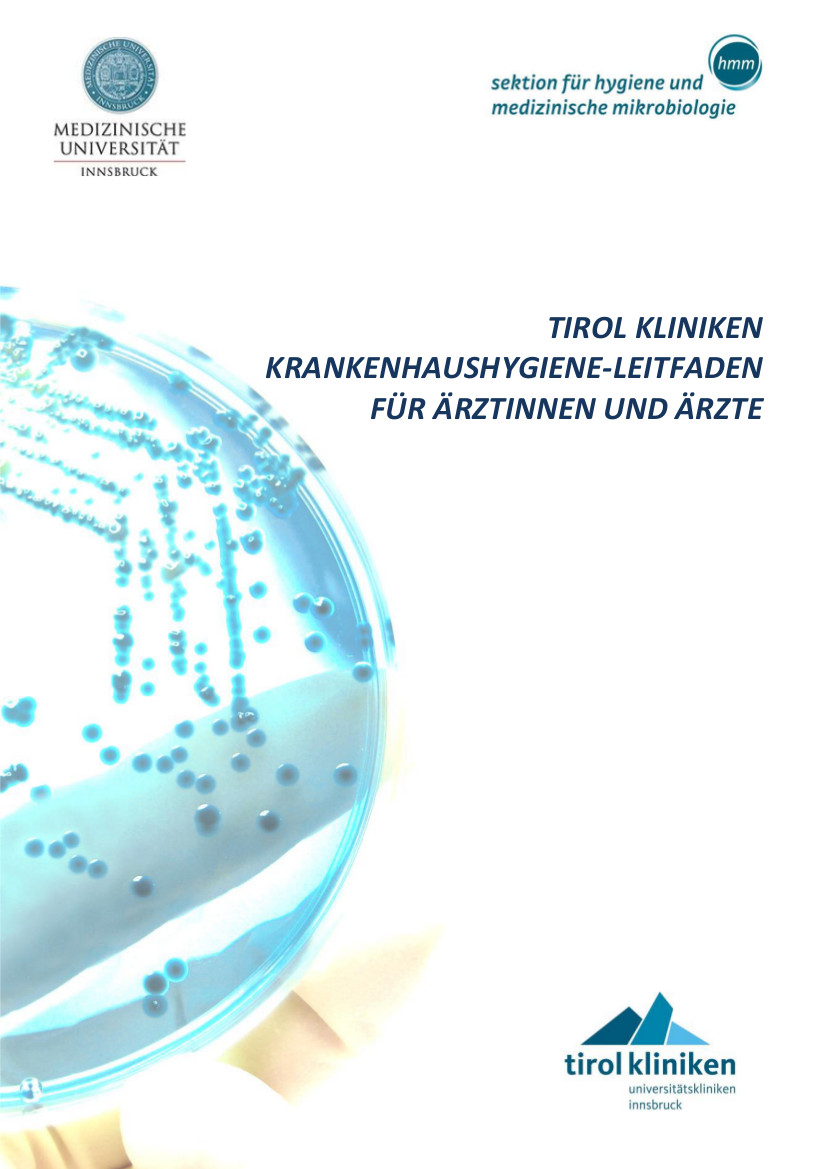
Hygieneleitfäden

zurück
-
-
-
-
- Department
Operative Medizin
- Department
Innere Medizin
- Department
Psychiatrie, Psychotherapie, Psychosomatik und Medizinische
Psychologie
- Department
Neurologie und Neurochirurgie
- Department
Frauenheilkunde
- Department Hals-,
Nasen- und Ohrenheilkunde und Hör-, Stimm- und
Sprachstörungen
- Univ.-Klinik für
Radiologie
- Department Zahn-,
Mund- und Kieferheilkunde und Mund-, Kiefer- und
Gesichtschirurgie
- Department
für Kinder- und Jugendheilkunde
- Alle Kliniken
- Department
Operative Medizin
-
-
-
zurück
-
-
-
-
- Department
Operative Medizin
- Department
Innere Medizin
- Department
Psychiatrie, Psychotherapie, Psychosomatik und
Medizinische Psychologie
- Department
Neurologie und Neurochirurgie
- Department
Frauenheilkunde
- Department Hals-,
Nasen- und Ohrenheilkunde und Hör-, Stimm- und
Sprachstörungen
- Univ.-Klinik für
Radiologie
- Department
Zahn-, Mund- und Kieferheilkunde und Mund-, Kiefer- und
Gesichtschirurgie
- Department für
Kinder- und Jugendheilkunde
- Alle Kliniken
- Department
Operative Medizin
-
-
-